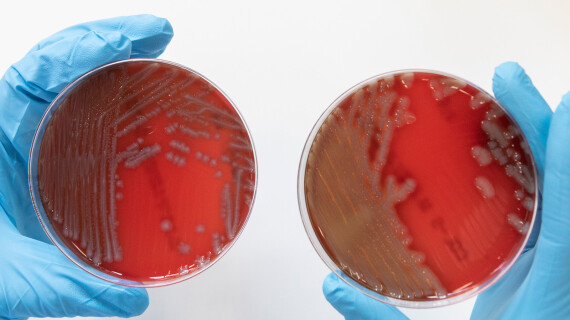
DVDW-header

Dag van de Wetenschap 2024

Op zondag 24 november staan onze onderzoekers voor jou paraat in ZOO Antwerpen om je ons onderzoek en onze wetenschap te laten ontdekken. Je leert via demonstraties, doe-activiteiten en spelletjes over uitbraken en hoe je ze kan voorkomen. Zorg jij er mee voor dat we de verspreiding van muggen en parasieten onder controle krijgen? Kom langs en help onze wetenschappers het hoofd te bieden aan kleine en grote ziekteverwekkers!
Voor Dag van de Wetenschap Antwerpen bundelen een heleboel partners de krachten om jong en oud een onvergetelijke dag te bezorgen! Antwerpse onderzoekers slaan de handen in elkaar en serveren je een overvloed aan wetenschap in de zalen van de ZOO. Met meer dan tachtig activiteiten transformeren we deze locatie tot een bruisend centrum van wetenschap en verbinding! Je kan er genieten van verrassende inzichten en de allernieuwste wetenschappelijke ideeën ontdekken.
Praktische info
Locatie: ZOO Antwerpen | Astridplein 26, 2018 Antwerpen
Prijzen:
Gratis | Zalen van de ZOO (ingang Koningin Elisabethzaal)
Met korting | Bezoek aan de ZOO
Onze activiteiten

Waterroofkever versus tijgermug
Lezing
De tijgermug breidt zich snel uit in Europa en vormt een gezondheidsrisico, waardoor milieuvriendelijke bestrijdingsmethoden nodig zijn. Onderzoek toont aan dat inheemse waterroofkevers een veelbelovende biologische oplossing kunnen bieden door effectief de larven van deze mug te bestrijden. Adwine Vanslembrouck vertelt graag over haar onderzoek en over hoe jij de strijd kan aangaan met de invasieve tijgermug.
Hoeveel bacteriën leven er op jouw hand?
Fysieke activiteit
Bacteriën maken van nature deel uit van elke gezonde huid en spelen een belangrijke rol in het beschermen van je lichaam tegen schadelijke micro-organismen. Benieuwd hoeveel bacteriën zich op jouw handen bevinden en welke soorten daar precies wonen? Maak een kweekje van je hand om te onderzoeken welke bacteriën er op jouw huid leven. Check je persoonlijke handafdruk om meer te leren over de microben die je dagelijks omgeven!

Hoe ziet een parasiet er nu echt uit?
Waarneming
Onze experts staan voor je klaar om je te leren werken met een microscoop en je meer info te geven over deze ziekteverwekkende kriebelbeestjes. Bekijk microscopische preparaten van verschillende soorten menselijke parasieten waaronder verschillende soorten Plasmodium (malaria), Trypanosoma (slaapziekte), Leishmania (leishmaniasis) en Loa loa (filariasis).

Malaria Outbreak: het coöperatieve kaartspel
Spel
Kunnen jullie de bevolking beschermen tegen de volgende uitbraak? Stap in de schoenen van een malariacontrole-expert, bescherm jezelf tegen malaria-verspreidende muggen en behandel besmette individuen, maar pas op voor resistente parasieten! Kom spelenderwijs meer te weten over malariabestrijding via dit spannende en coöperatieve kaartspel. Voor groepen van twee tot tien spelers, zowel voor kinderen als volwassenen.

Leer alles over ziekteverwekkers en voorkom mee de volgende uitbraak!
Spel
Samen met onze wetenschappers leer je via demonstraties, doe-activiteiten en spelletjes over uitbraken en hoe je ze kan voorkomen. Zorg jij er mee voor dat we de verspreiding van muggen en parasieten onder controle krijgen? Kom langs en help onze wetenschappers het hoofd te bieden aan kleine en grote ziekteverwekkers!

Gezondheidszorg voor iedereen ter wereld: is dit mogelijk?
Podcast
Deze podcast neemt je mee met onze onderzoekers in hun nooit aflatende zoektocht naar een gezondere wereld. De reis brengt hen helemaal van oorlogsgebieden naar inheemse gemeenschappen om dringende problemen aan te pakken zoals moedersterfte, het hardnekkige stigma rond hiv en het gebrek aan toegang tot levensreddende medicijnen.

Hoe ontstaan uitbraken? En hoe stop je ze?
Podcast
We ontrafelen de geheimen van infectieziekten en nemen je mee op reis met experts die zich inzetten voor de verbetering van de wereldgezondheid. Van vroege confrontaties met ebola en mpox in afgelegen dorpen tot de recente strijd tegen COVID-19 in levendige stedelijke gebieden: dit zijn verhalen van veerkracht, ontdekking en menselijkheid in de meest uitdagende situaties.

Meer informatie
Verken alle activiteiten en praktische informatie op de website van Dag van de Wetenschap.
Neem een kijkje in de brochure van Festival Antwerpen.
Bekijk de richtlijnen rond bereikbaarheid van ZOO Antwerpen.
Spread the word! Deel dit evenement op